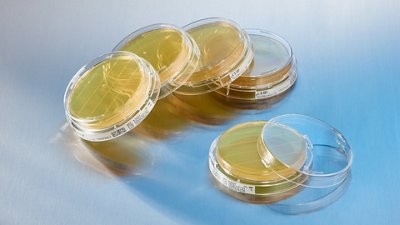

3P® ENTERPRISE
EM-POWER THE FUTURE
Bridging the gap between standard processes and automation, 3P® ENTERPRISE transforms the future of environmental monitoring in the pharmaceutical industry.
From sampling to trending, take control with an end-to-end, fully digitalized and automated workflow. Increase efficiency and help ensure your products are safe and compliant with an innovative environmental monitoring system.



- Benefits
- Features
- Videos
- Resources
3P® ENTERPRISE is a fully integrated environmental monitoring (EM) solution designed to optimize your EM program and always keep your operations under control. The traceable culture media 3P® SMART PLATES are now enhanced with a GS1 barcode and clear design to enhance the reliability of your data. Tracking is continuous throughout the entire EM workflow through the user-friendly 3P® CONNECT SOFTWARE. Combined with the 3P® STATION, a system that automates the incubation and reading of standard Petri dishes, you reach end-to-end maximum efficiency and improve compliance.

Benefits
- IMPROVE PROCESS EFFICIENCIES: Time saving processes and faster responsiveness enable resources to be allocated more effectively to value-added tasks, and production capacity to be maximized.
- REDUCE ERRORS AND ASSOCIATED COSTS: User guidance at any time with alarms and conformity checks reduce the risk of errors & associated costs.
- BENEFIT FROM REAL TIME TRACEABILITY, SECURE DATA INTEGRITY AND COMPLIANCE: To be audit ready at any time with 21 CFR PART 11 compliance, ALCOA+ principle and cybersecurity by design.
- ENSURE ROUTINE USE AND CONTINUOUS OPERATIONS WITH MAXIMUM UPTIME: 3P® ENTERPRISE is a flexible, integrated solution that adapts to your organization. End-to-end services enable seamless, facilitated implementation and validation to ease and accelerate the uptime of the solution.

Features
MEET THE 3P® STATION. To make the colony counting process less cumbersome and more robust, 3P® STATION has been developed with several high-level technical features specifically for pharmaceutical environmental monitoring:
- Robust reading performance: To ensure the best reading performance, the 3P® STATION uses a kinetic reading approach. Images of plates are taken every hour during the incubation cycle by a high-resolution camera. Your counting results are standardized and supervised in real-time, allowing you to be alerted as soon as a sample is out-of-specification.
- Enhanced samples traceability: Samples are tracked by their unique ID number. Data and images of the plates are available anywhere and anytime for review and archiving.
- Layout flexibility: Each 3P® STATION holds up to 300 plates and instruments can be flexibly laid out across QC lab or your manufacturing lines to fit with your process requirements and efficiency objectives.
- Incubation modes: The 3P® STATION has been developed to comply with your incubation practices whether you are using single temperature or double temperature cycles.
EASE OF USE
- Users are guided all along the workflow (scan plates, intuitive software and system)
- Supervision and validation of all samples facilitated
- Full paperless and automated EM process
ERROR AVOIDANCE
- Ensure expiration date, plate type, sampling & incubation durations to avoid errors
- Benefit from a real-time, complete traceability and tracking of samples
- Rely on alerts and alarms along the process
DATA ANALYSIS & REPORTING
- Full and centralized data
- Trending and reporting
- Audit trail & alarm reports
- Production and laboratory view for supervision of samples
3P® ENTERPRISE: EM-POWER THE FUTURE
Bridging the gap between standard processes and automation, 3P® ENTERPRISE revolutionizes the future of EM. From sampling to trending, keep control with an end-to-end fully digitalized and automated workflow, increase your efficiency and ensure your products are safe and compliant.
Meet the 3P® STATION
To make the colony counting process less cumbersome and more robust, 3P® STATION has been developed with a number of high level technical features. Discover them in this video!
BROCHURE - 3P ENTERPRISE: Fully Automated Enviromental Monitoring
EM-POWER THE FUTURE
- Filename
- 25-BMX-3P-ENTERPRISE-Brochure-2025.pdf
- Size
- 8 MB
- Format
- application/pdf
BROCHURE - OPTIMAL - Service Contract
DOWNLOAD BROCHURE
- Filename
- bioMerieux_3PEnterprise_CyberSecurity_Brochure.pdf
- Size
- 1 MB
- Format
- application/pdf
BROCHURE - Cybersecurity
DOWNLOAD BROCHURE
- Filename
- BMX_Partnership_Assist_Brochure_A4_v6_final_DIGITAL (1).pdf
- Size
- 1 MB
- Format
- application/pdf
BROCHURE - Creating Value by Harvesting the Full Potential of your Bioprocessing Testing
DISCOVER OUR COMPREHENSIVE PORTFOLIO
- Filename
- PHARMA-BROCHURE-CGT-ACCELLIX-A4-05-23-9324115-Pages.pdf
- Size
- 2 MB
- Format
- application/pdf
BROCHURE - Boost Cell & Gene Therapy Production Efficiency
DISCOVER OUR COMPREHENSIVE PORTFOLIO
- Filename
- Brochure_Bioproduction_A4_9324117_web.pdf
- Size
- 5 MB
- Format
- application/pdf
WHITEPAPER - New Standardized Methodology to Evaluate Environmental Monitoring Plates Inspection Using an Automated System.
DOWNLOAD WHITEPAPER
- Filename
- 3P_Whitepaper_Introduction_to_a_New_Standardized_Methodology_for_EM_21382 DIGITAL.pdf
- Size
- 938 KB
- Format
- application/pdf